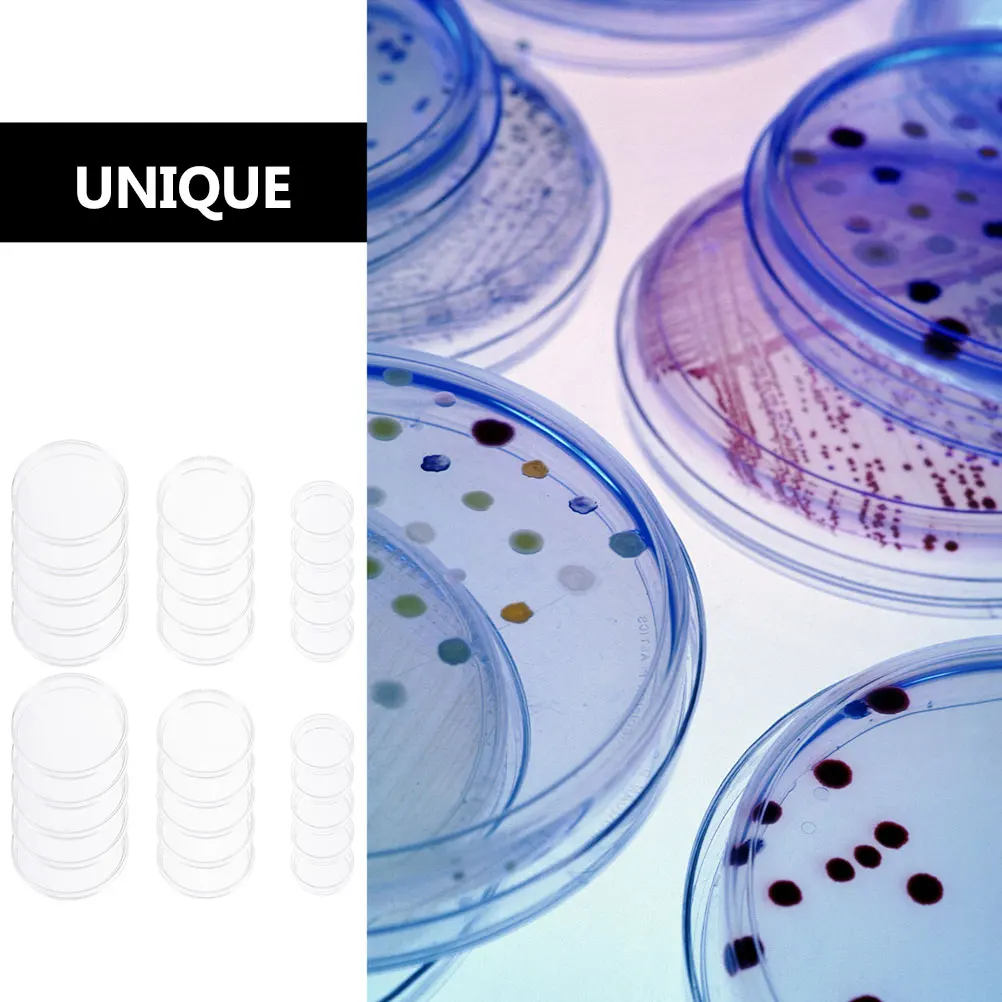

party favor quicksand cat pencil case cute bag three layers big pen girls kawaii stationery cartoon animals student


sku: 718598679
ACCORDING TO OUR RECORDS THIS PRODUCT IS NOT AVAILABLE NOW
1,493.62 руб.
Shipping from: China
Description
welcome to our store,we are devoted to offer products with reasonable wholesale price and fast delivery,our company is professional in e-business,your order will be sent our with 1-3 days after we receive order payment,you will be satisfied with the shopping experience in our store.please check the size information before you place the order,all dimensions are measured by hand,there may be some little deviations.hoping you are understand it,look for long term business with you.
Technical Details
| _GoogleCategoryID: | 2559 |
Price history chart & currency exchange rate
Customers also viewed

437.00 руб.
10 листов наклеек для ногтей, двухсторонние клейкие вкладки, водонепроницаемые, дышащие, наклейки для накладных ногтей, желеобразные накладные ногти
joom.com
3,684.00 руб.
Весенне-осенний женский пижамный комплект из 100% хлопкового крепа с длинными рукавами, симпатичный домашний комплект из двух предметов для женщин M
joom.com
2,582.00 руб.
2024 Брендовые женские туфли с пряжкой на ремешке, женские босоножки, модные босоножки с открытым носком, женские летние босоножки больших размеров на каблуке 36 покинуть белый
joom.com
1,195.00 руб.
Сохраняет тепло, мягкая кроватка для домашних животных, круглая бархатная кроватка для котят премиум-класса L жёлтый
joom.com
729.00 руб.
Автомобильное зарядное устройство для телефона, 2 порта, универсальный источник питания
joom.com
6,555.12 руб.
ЖК-дисплей 5,8 дюйма 240*128 LMBHAT014GC M214CP1A, промышленный ЖК-дисплей 4:3, ЖК-экран (можно добавить сенсорный экран), новая Замена ЖК-дисплея
aliexpress.ru
3,318.94 руб.
Оригинальный контроллер материнской платы 462919-001 013233-001 Array SAS P410 6 ГБ для контрольной карты сервера PCI-E RAID5 FBWC 512M 1G кэш
aliexpress.ru
4,425.26 руб.
Wkooa 4x14 диаметр 4 мм Длина 14 мм нейлоновый держатель для печатной платы светодиодный держатель
aliexpress.ru
2,849.37 руб.
Арабский кальян, полный KTV-бар, двойная трубка, Орел, средний бытовой кальян, кальян, полный кальян
aliexpress.ru
8,632.53 руб.
Скандинавский светодиодный каменный подвесной светильник, Подвесная лампа, люстра для кухни, столовой, бара, гостиной, спальни
aliexpress.ru
1,359.54 руб.
Оригинальное винтажное китайское черное традиционное платье Ципао 2021, новое повседневное женское платье миди для вечеринки, летние платья Ципао
aliexpress.ru
2,127.21 руб.
baby boys clothes summer kids cartoon clothing infant suit toddler t-shirt pants set for 0 1 2 3 year baby casual track suit, White
dhgate.com
2,550.00 руб.
Сапоги для охоты Дарина Иваныч ICE Land Д343-НУ, черный, 45/46 RU, Иваныч ICE Land
goods.ru
5,355.38 руб.
Men's Shoes Winter New Large Size Cotton Shoes For Men Plus Velvet High Top Sports Shoes Outdoor Snow Boots Martin Hiking Shoes
aliexpress.com
1,081.73 руб.
Ladies Fashion New V-neck Short Sleeve Line Print Midi Dress Summer A-line Dress
aliexpress.com
2,033.98 руб.
Women's Jeans High Waist Buttocks Lace-Up Jeans Autumn Personality Jeans Street Casual Pants
aliexpress.com
7,172.77 руб.
slipper fine women's sales designer slippers everyday metal decorate woman's toe round genuine autumn slides mujer zapatos y95g, Black
dhgate.com
355.66 руб.
Sexy Exotic Lace Bras Transparent Openwork Emotional Chest Buckle Elastic Back Vertical Tie Women Bra
dhgate.com
90.96 руб.
Fashion Crystal Gold Silver Color Metal Barrettes Imitation Pearl Rhinestone Hair Clips For Women DIY Hairgrips Hair Accessories
aliexpress.com
762.95 руб.
Women Nylon Backpack for Teenagers women Ladies Bags Marbling Backpack Female Computer High Quality Rucksack Schoolbag Feminina
aliexpress.com
102.44 руб.
2pcs Massage Stick Natural Wood Foot Body Acupoint Therapy Tool Manual Roller Tension Relief Traditional Wooden
aliexpress.ru
401.55 руб.
Набор G2AC из 2 USB в RJ45 сетевые адаптеры Ethernet для стабильной передачи данных
aliexpress.ru
247.49 руб.
Real 925 Sterling Silver Geometric Mini Stud Earrings for Charm Women Trendy Party Fine Jewelry Minimalist Accessories Ear hole
aliexpress.ru
3,090.31 руб.
Комплект светодиодных фонарей «сделай сам» для строительных блоков гоночных автомобилей в стиле F1 42206 (только светильник, без кирпичей в комплект)
aliexpress.ru
668.71 руб.
MOTORCYCLE PARTS HANDLE LEVER SET BRAKE LEVER HANDLE LEVER ACCESSORIES FOR YAMAHA XTZ125 XTZ250 FAZER250 FZ25
aliexpress.ru
425.32 руб.
30pcs Culture Dish Petri Clear Plates with Lid for Science Projects Disposable Plastic Petri Dish Lab Use Plastic Material
aliexpress.ru
2,083.97 руб.
AAAN-магнитный рабочий фонарь, перезаряжаемый рабочий светильник под капотом, ремонт автомобиля, наружное освещение
aliexpress.ru![CASIO Женские часы Casio Baby-G BA-120-2B [предмет] синий
CASIO Женские часы Casio Baby-G BA-120-2B [предмет] синий](http://img.joomcdn.net/1bd4f69edd71ad42814e2fda8feafbb4d8cd3233_original.jpeg)
















